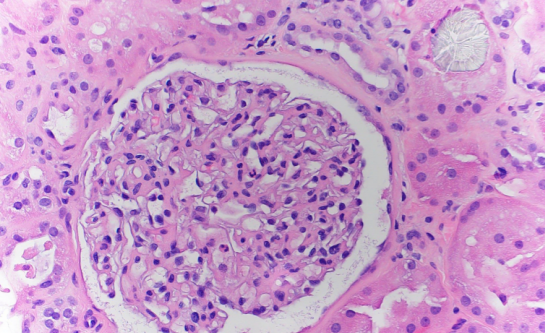

来源:医博士 | 2022-03-14 作者:李胜佳
烟雾吸入是火灾相关事件导致死亡的主要原因,因为它会导致肺部和上呼吸道的热损伤;燃烧物副产物造成的化学伤害;以及一氧化碳和氰化物等有毒物质。
氰化物可抑制多种酶,包括导致细胞缺氧、心血管衰竭和死亡的细胞色素氧化酶。氢氧化钴胺素是维生素B12的一种天然形式,可螯合氰化物,从而形成由肾脏排泄的氰钴胺,已被越来越多地用作氰化物中毒的解毒剂。
然而,法国的一项回顾性研究发现,吸入氢氧钴胺素与急性肾损伤(AKI)风险增加和需要肾脏替代治疗相关。此外,另一项研究报告称,接受羟钴胺治疗的患者尿草酸水平较高。关于羟钴胺诱发草酸盐肾病AKI的报道很少。
本病案报告一例因吸入烟雾而入院的患者,经活检证实为羟钴胺诱导的草酸肾病。
病例介绍
一名54岁男性,有酗酒史,因长期暴露在火灾烟雾中而被送往医院。在途中,因怀疑氰化物中毒而接受了氢钴胺静脉注射。到达时,患者迷失了方向,但血流动力学稳定,没有皮肤烧伤。
实验室检查显示,血氧饱和度最初为90%,使用氧气面罩时增加到100%。患者的尿液呈红色,但尿液分析显示没有蛋白尿,尿液显微镜也没有检测到红细胞、白细胞或管型。胸片未见异常。氰化物水平无法检测,但碳氧血红蛋白水平升高至10.8%(正常范围为0.0%–1.4%),与一氧化碳中毒一致。患者口腔粘膜周围有碳烟灰,需要增加氧气补充。由于担心吸入性肺损伤,进行了气管插管以保护气道,然后被转移到重症监护病房。支气管镜检查显示气道中有黑色碳质物质,但没有烧伤的迹象。在重症监护病房,患者出现低血压,需要积极的容量复苏和血管升压药支持。患者还患有代谢性酸中毒,动脉pH值为7.21,因此开始进行碳酸氢钠输注。
第2天,患者出现AKI,血清肌酐从基线水平0.86上升至2.1 mg/dl。肾脏超声检查未发现异常。在住院第三天,患者拔管,但肾功能继续恶化,血清肌酐上升至5.93 mg/dl。由于使用羟钴胺,尿液呈暗红色,排尿量逐渐减少,直到无尿。虽然患者的血流动力学稳定,但开始接受持续性肾脏替代治疗,而不是血液透析,以避免因体液红色尿液而忽略血尿。
患者的AKI病因尚不清楚,因为只是短暂低血压,没有服用肾毒性药物。怀疑草酸肾病是因为他的24小时尿草酸浓度为40mg(参考范围16-49ml/d),血清草酸浓度为22.5mmol/L(参考范围≤1.9). 在第4天进行肾活检以确定其AKI的原因。组织学检查显示轻度急性肾小管坏死和微小的间质纤维化。还显示肾小管内广泛的草酸钙晶体沉积,在偏振光下观察时具有特征性的明亮双折射(图1和图2)。患者在入院前否认有任何高草酸饮食史、减肥手术史、炎症性肠病史或任何药物使用史。因此,肾活检结果证实了继发性草酸肾病的诊断,继发性草酸肾病归因于服用羟钴胺。在第5天,患者从连续性肾脏替代治疗过渡到间歇性血液透析。配合低草酸饮食、口服醋酸钙和吡哆醇,每天5 mg/kg。随着时间的推移,患者的排尿量有所改善,但在出院时仍依赖透析。患者最终从AKI中康复,血液透析在出院1个月后停止。

图1
图2
结论
本病案报告了一例罕见的羟钴胺诱发草酸肾病。鉴于静脉注射氢钴胺素作为氰化物中毒的一线治疗方案,因此怀疑像这样的草酸盐肾病病例可能会被更频繁地诊断出来。临床医生应该意识到静脉注射氢氧钴胺素的这种潜在严重并发症。这种并发症的范围及其潜在机制还有待于进一步研究。
医博士编译自:Evans J, PandyaA, Ding Y, et al. Hydroxocobalamin-Induced Oxalate Nephropathy in a Patient With Smoke Inhalation. Kidney International Reports. 2021; 6(8):2228-2231.
声明: 所有注明“来源:医博士”的文字、图片和音视频资料,版权均属于医博士所有,转载须注明“来源:医博士”;所有转载文章系出于传递更多信息之目的,且明确注明来源和作者,不希望被转载的媒体或个人可与我们联系,我们将立即进行删除处理。